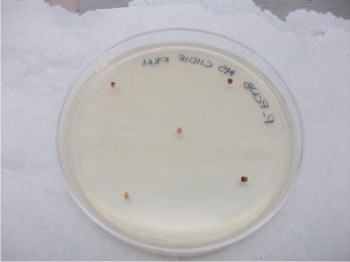

Este paquete se compone de criterios de preparación de terreno, selección de híbridos para siembra, métodos de siembra, fertilización en dosis variables, labores culturales, riego por pulsos, control de maleza, control de plagas, control de enfermedades y criterios de cosecha
Este paquete se compone de criterios de preparación de terreno, selección de híbridos para siembra, métodos de siembra, fertilización en dosis variables, labores culturales, riego por pulsos, control de maleza, control de plagas, control de enfermedades y criterios de cosecha
El laboreo excesivo, el establecimiento de altas densidades de población en la siembra, el uso inapropiado de los insumos, el mal control de plagas, el mal uso del agua, y la carencia de criterios para una buena cosecha, son factores que ocasionan desde altos costos de producción hasta disminución en los rendimientos.



 Se busca promover la importancia de la pasteurización de la leche y que los queseros y productores de leche sinaloenses puedan producir más y mejores variedades de quesos
Se busca promover la importancia de la pasteurización de la leche y que los queseros y productores de leche sinaloenses puedan producir más y mejores variedades de quesos  Sinaloa ocupa el lugar 13 de los estados productores de papaya, con 190 hectáreas sembradas y un rendimiento de 36.93 toneladas por hectárea. La principal área productora está en el sur del municipio de Mazatlán, en El Roble, Siqueros, San Francisquito y Cofradía
Sinaloa ocupa el lugar 13 de los estados productores de papaya, con 190 hectáreas sembradas y un rendimiento de 36.93 toneladas por hectárea. La principal área productora está en el sur del municipio de Mazatlán, en El Roble, Siqueros, San Francisquito y Cofradía El proyecto busca seleccionar la mejor combinación o mejor bacteria para el control de Fusarium, desarrollar la producción masiva de los antagonistas, realizar una segunda evaluación de los mejores, y evaluar las bacterias para definir su uso
El proyecto busca seleccionar la mejor combinación o mejor bacteria para el control de Fusarium, desarrollar la producción masiva de los antagonistas, realizar una segunda evaluación de los mejores, y evaluar las bacterias para definir su uso